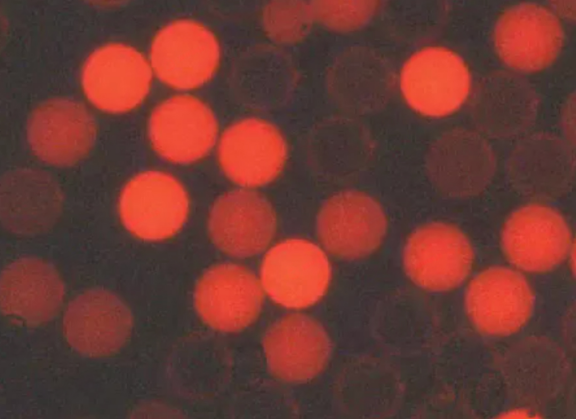
image.png 賽默飛世爾Thermo Fisher微粒微球 產品介紹

PRODUCT CLASSIFICATION
產品分類
更新時間:2026-01-23
瀏覽次數:46賽默飛世爾Thermo Fisher微粒微球
——杜克標準粒子/Duke微粒、質控微球、熒光微球
北京云肽生物科技代理的美國進口賽默飛世爾Thermo Fisher微粒(微球)產品,包括杜克標準粒子(杜克微粒/Duke微球)、質控微球、熒光微球等,擁有超過50年的研發和生產應用經驗,提供20nm~2000μm的廣泛粒徑,可溯源至美國國家標準與技術研究院NIST的標準度量單位,為quan球zhi名科研院校、制藥機構、IVD實驗室和制造商提供專業的儀器校準、 顆粒分析、質控計數、效能研究、系統評估、IVD研發等解決方案。
Thermo Fisher微粒提供超過482款產品,包括:
NIST溯源尺寸標準微粒(杜克標準粒子)
計數質控微粒
流式細胞微粒(流式質控微球)
染色微粒
熒光微粒
專業微粒
乳膠微粒
一、NIST溯源尺寸標準粒子——杜克標準粒子
Thermo賽默飛杜克標準粒子(杜克微粒/Duke標準微粒/Duke微球)有聚苯乙烯和玻璃兩種材質,標稱直徑覆蓋20nm~2000μm,適用于尺寸測量儀的研發、標準化與驗證、光學和電子顯微鏡測定、光散射研究、膠質系統研究、半導體SISS系統校準等。Thermo杜克微粒提供完整表征,包括平均直徑、平均直徑的不確定度、標準偏差和變異系數。豐富的產品表征為Thermo一系列杜克微球提供了更高置信度水平,讓儀器校準和驗證的結果更具可信性。Thermo Duke微粒的尺寸結果是NIST可追溯的,用于尺寸校準不僅可獲得更準確的結果,對于其他復雜方法的檢驗進行認證也可獲得更好的關聯,應用也更易執行。
Thermo有超過50年專業制備單分散微球的經驗和特殊工藝技術。為了協助儀器設備的研發、標準化與精準驗證, Thermo將NIST溯源的單分散聚合微球開發為一系列用于校準、認證和優化分析的標準尺寸微球產品。
1、校準方法——改進的單分散球形顆粒尺寸校準法
單分散或高度均勻的球體,當放置在液體介質中的平坦表面上時,其自身排列成系統的六邊形陣列。使用顯微鏡,可以測量一行的長度,并除以該行中球體的數量,以計算球體的平均直徑。自1977年以來,Thermo實驗室一直在研究檢測球形顆粒平均直徑的陣列方法。
圖.單一微球邊緣難以界定
如上圖所示,此方法的研發就是為了解決球形顆粒圖像的邊緣難以高精度確定的問題。當球體在平面上以直線排布時,定義陣列中di一個和zui后一個粒子的外邊緣的不確定性,與定義單個粒子的兩個邊緣的不確定性相同。當不確定性除以行中的球體數量時,每個球體的邊緣不確定性變得更低,很大程度提高了平均尺寸確定的精度。下圖展示了一個典型的微球陣列。
圖.單分散陣列排布后的微球尺寸鑒定
利用改進的尺寸校準法,Thermo對一系列0.5~40μm的單分散球形顆粒進行了校準,并用美國國家標準與技術研究院(NIST)校準的載物臺千分尺進行了驗證。
2、校準溯源——載物臺千分尺
校準標準是由美國國家標準與技術研究所(NIST)通過激光干涉測量法校準31個間隔的載物臺千分尺。根據NIST報告#5524,長度小于0.2mm(用于校準目鏡分劃板的最長長度)時,測微計校準的不確定度小于0.00004mm(0.04µm)。
3、驗證標準——NIST認證粒度標準
Thermo內部的標準粒子和來自NIST和BCR兩個機構的6個認證粒度標準被用作驗證標準,用改進的陣列方法測量它們的球徑。通過光學陣列方法校準分析三種BCR標準參考物質為CR#165A(2.223µm)、BCR#166A(4.821µm)和BCR#167A(9.475µm),三種NIST參考材料分別為SRM#1690(0.895µm )、SRM#1960(9.89µm)和SRM#1961(29.64μm)。
4、校準結果——與認證直徑的比較

以上12種微粒經認證的參考標準和Thermo通過陣列法計算得到的微粒直徑,幾乎沒有偏差,測量值均在標準不確定度范圍內。光學陣列法wan全可以勝任納米顆粒直徑的校準,Thermo生產的杜克標準粒子,可勝任各種情況下的量值溯源和檢測校準。
Thermo杜克標準粒子產品
2000系列Duke標準微粒(代表貨號:2005A~2040A)
3000系列納米尺寸標準粒子(代表貨號:3020A~3900A)
4000系列Duke標準微粒(代表貨號:4009A~4400A)
8000系列Duke標準微粒(二氧化硅)
9000系列Duke標準微粒(硼酸鹽)
Chromosphere-T 認證尺寸標準粒子(黑色/紅色)
Dri-Cal系列尺寸標準干微粒(聚合物干燥標準微球,代表貨號:DC05~DC100)
Surf-Cal系列尺寸標準粒子(半導體晶片檢測微球,代表貨號:PD047~PD3000)
4D系列尺寸標準粒子(ISO21501-4標準)
二、計數質控微粒
Thermo計數質控微粒可溯源至美國標準品與技術研究院(NIST)標準參考物質(SRM),標稱直徑在100nm~100μm,適用于氣體或液體微粒計數儀的校準、注射類藥物與眼藥水生產商USP中期驗證、飲用水質量優化等。
Thermo計數質控微粒產品
3K/4K系列Duke標準微粒(代表貨號:3K-100~4k-100)
Count-Cal液體計數質控微球(代表貨號:CC02-PK~CC70-PK)
Ezy-Cal液體計數質控微粒(液體計數標準微球,代表貨號:6002~6070)
Pharm-Trol計數質控微粒(USP內部認證計數微球,代表貨號:CS-PK~CS-BX)
Validex計數質控微粒(超純水計數微球,代表貨號:CRS-05~CRS-10)
三、流式細胞技術微粒
Thermo流式細胞技術微粒是用于流式細胞儀的第三方校準質控品,包含488和633校直微粒。
Thermo流式細胞技術微粒產品
Cyto-Cal流式細胞儀校直微粒(488nm/633nm)
Cyto-Plex流式細胞儀熒光微粒(羧基修飾)
四、ChromoSphere染色微粒
Thermo ChromoSphere染色微粒采用Color-Rich內部深度染色工藝,直徑分布于50μm~500μm,有紅色和黑色可選,可與背景材料形成強烈的對比與可見度。

Thermo染色微粒產品
ChromoSphere 染色干微粒(黑色/紅色)
五、Fluoro-Max熒光微粒
Thermo科研用Fluoro-Max熒光微粒采用特殊的Firefli內部染色工藝,可避免染料在液體中滲濾,有綠色、紅色和藍色可選,適用于優化傳統顯微鏡分析功能、污染控制的定性和定量測定、流體追蹤、過濾測試和孔徑評估等。
IVD用Fluoro-Max熒光微粒,te有的內部染色工藝,防止染料在溶液中滲漏;寬廣的斯托克斯位移, 激發光360nm,發射光613nm,保證了高靈敏度和低背景干擾;更強的熒光強度和色飽和度,提供更佳的試驗靈敏度和判讀,為實現高靈敏度的側向免疫層析檢測提供了重要原料。
Thermo熒光微粒產品
Fluoro-Max 綠色、紅色、藍色熒光微粒溶液(科研)
Fluoro-Max 綠色、紅色干熒光微粒(科研)
Fluoro-Max羧基修飾銪螯合熒光微粒(IVD)
Fluoro-Max鏈酶親和素銪螯合熒光微粒(IVD)
六、專業微粒
Thermo專業微粒直徑覆蓋0.03μm~222μm,應用于過濾系統評估、光散射研究、流體動力學研究、氣霧劑研究、分散研究、煙霧探測等科研領域,但不適用于儀器校準或IVD試劑領域。
Thermo專業微粒產品
5000系列微粒懸浮液(尺寸標準微球,過濾和氣溶膠研究,代表貨號:5003A~5320A)
7000系列共聚物微粒懸浮液
七、Color-Rich染色微粒
IVD用Thermo Color-Rich羧基修飾染色微粒,采用Color-Rich內部深度染色方法,可防止染料滲漏,不會干擾蛋白結合,色彩飽和度佳,靈敏度、特異性和穩定性超高,為側向免疫層析和玻片凝集測試的試劑開發提供了更佳性能。
Thermo染色微粒產品
Color-Rich羧基修飾染色微粒(藍色/紅色/黑色)
八、乳膠微粒
IVD用Thermo Opti-Bind/Opti-Link乳膠微粒,主要應用于玻片凝集測定、懸浮陣列試驗和比濁試驗;開瓶即用,無需任何預清洗,操作簡便;特殊的陰離子表面活性劑,不會干擾蛋白結合,也不會導致蛋白質從微粒表面解吸附;微粒表面帶有多種修飾基團,適用于不同的交聯方法;不含常見的會干擾蛋白結合的表面活性劑。
Thermo乳膠微粒產品
Opti-Link羧酸鹽修飾微粒
Opti-Bind硫酸鹽微粒
Powder-Bind鏈酶親和素包被微粒